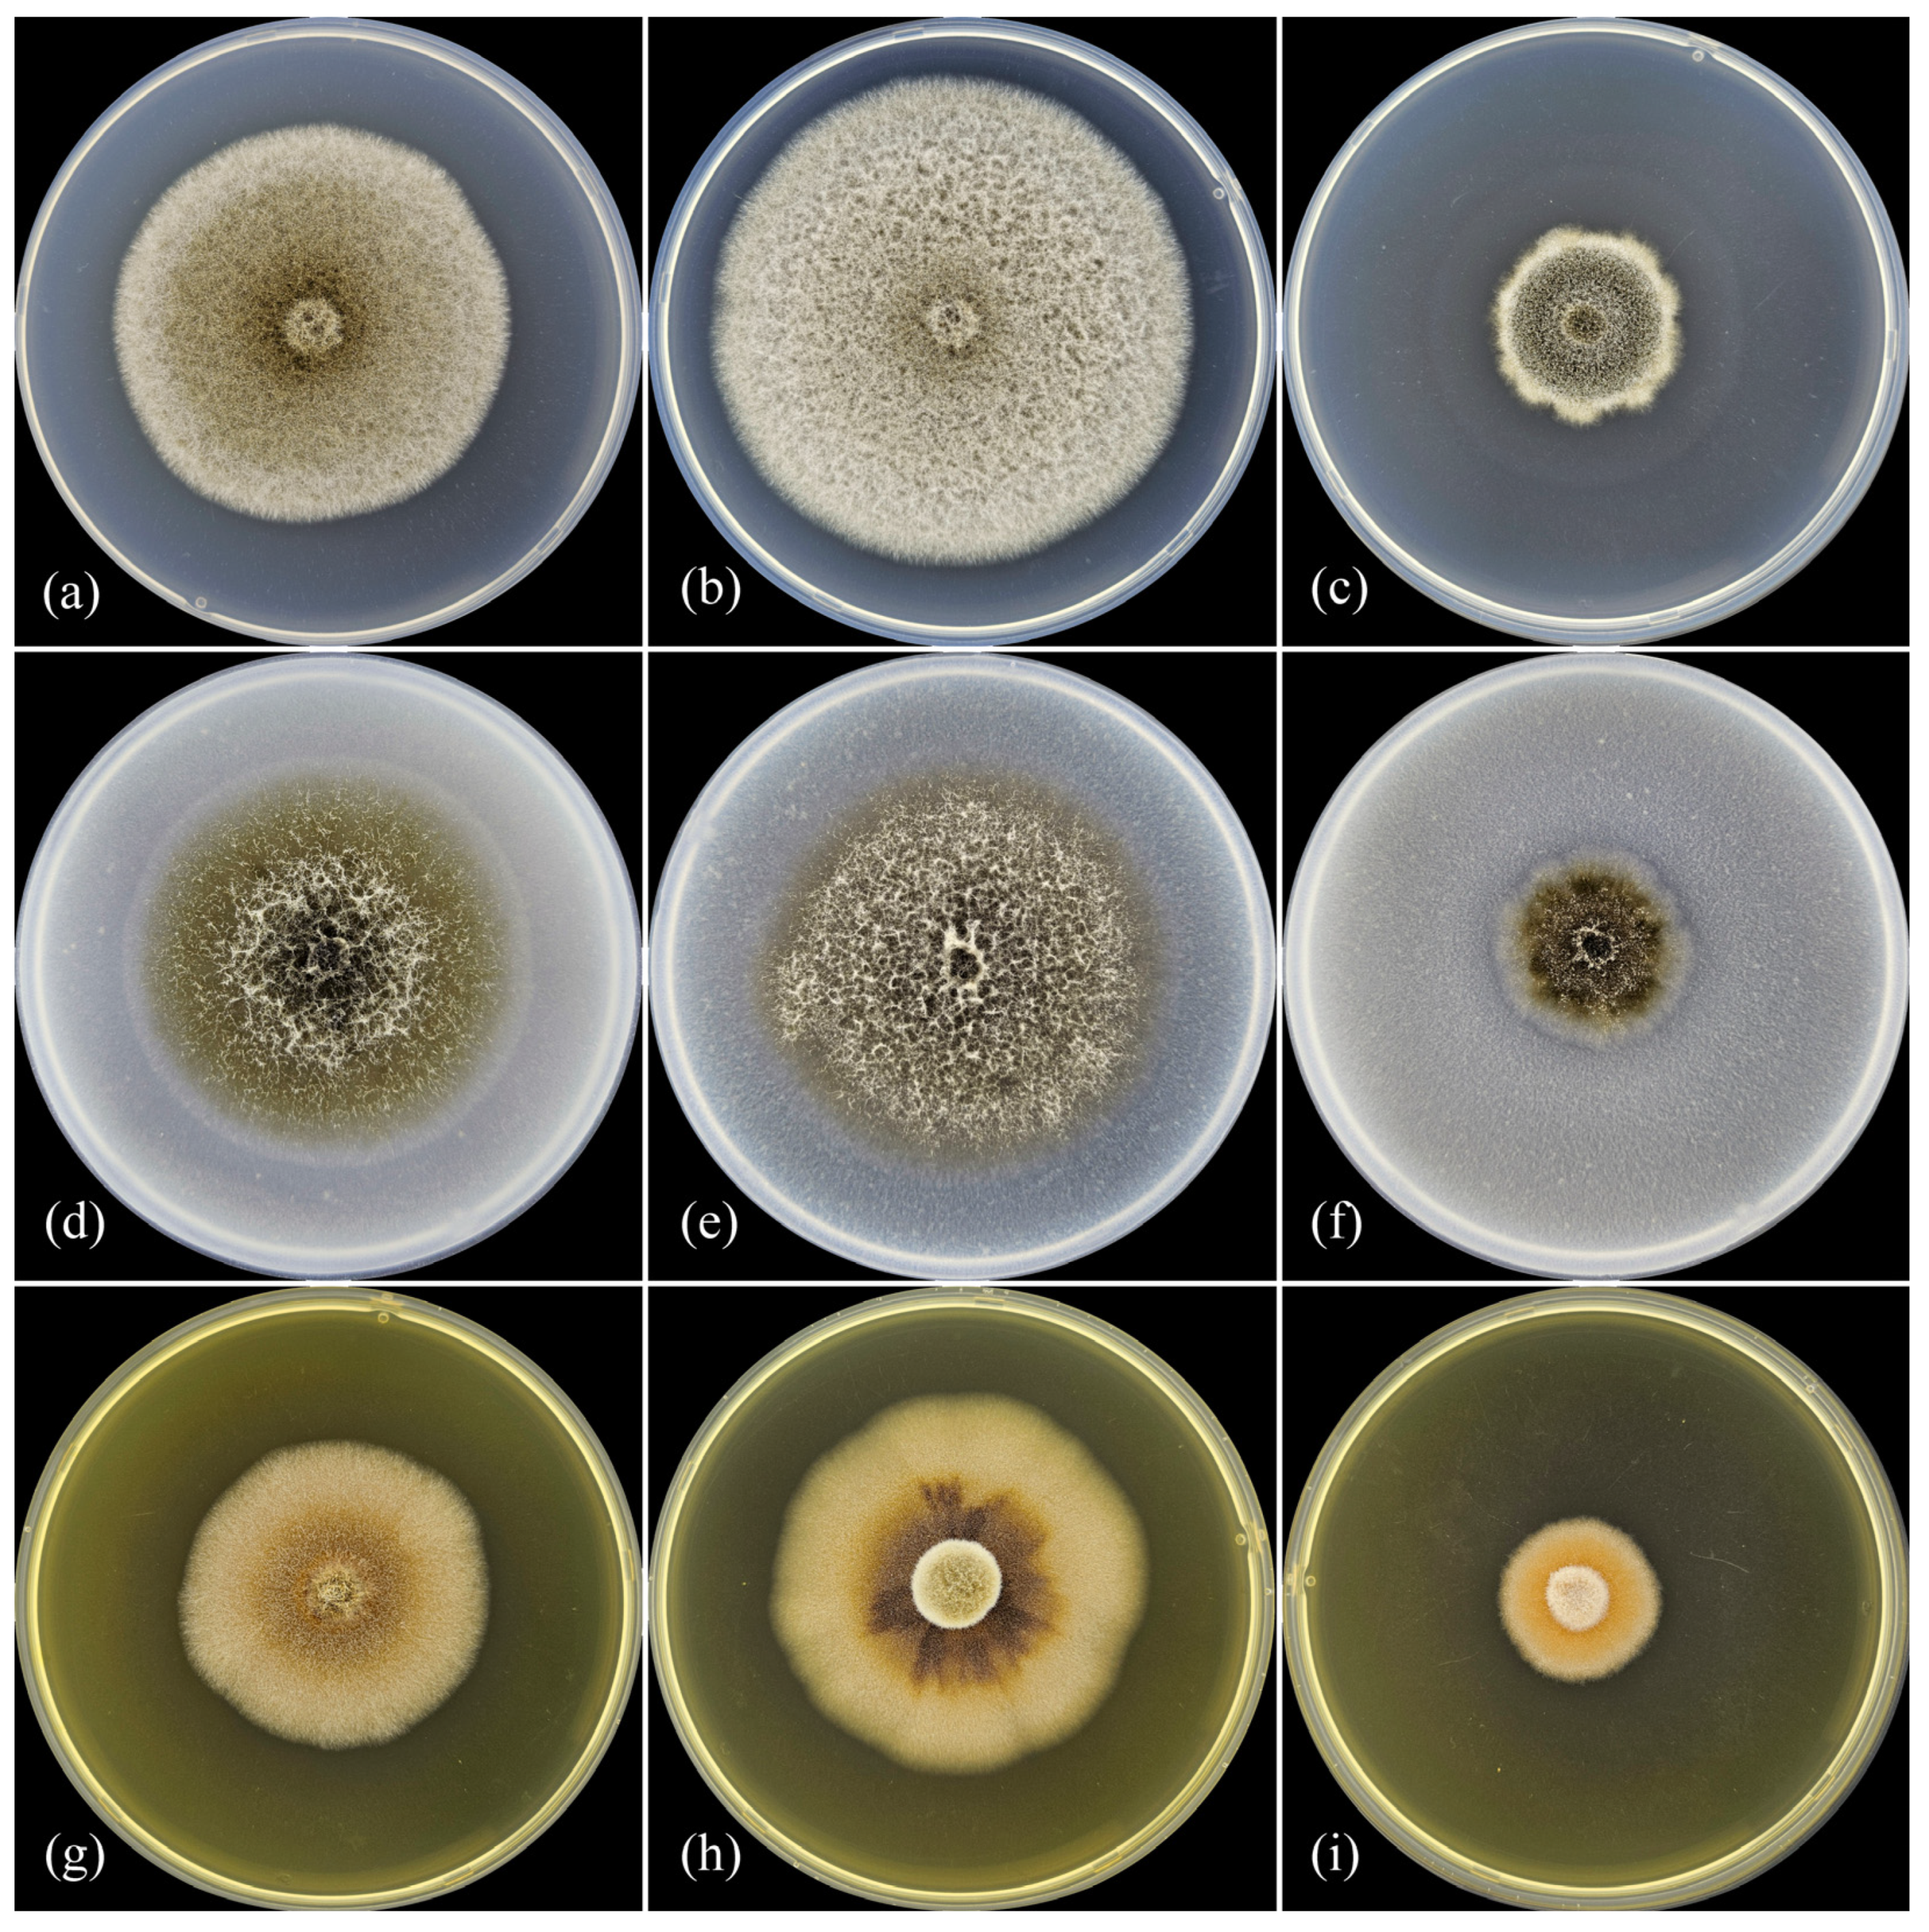
Diversity 16 00246 g002

Ascochyta erotica sp. nov. Pathogenic on Convolvulus arvensis
Abstract
:1. Introduction
2. Materials and Methods
2.1. Plant Material
2.2. DNA Isolation, PCR, and Sequencing
2.3. Phylogenetic Analyses
2.4. Morphology
2.5. Optimal Temperature for Growth
2.6. Pathogenicity
3. Results
3.1. Phylogenetic Analyses
3.2. Optimal Temperature for Growth
3.3. Taxonomy
3.4. Pathogenicity
4. Discussion
Supplementary Materials
Author Contributions
Funding
Institutional Review Board Statement
Data Availability Statement
Acknowledgments
Conflicts of Interest
References
- Libert, M.-A. Plantae Cryptogamicae, quas in Arduenna Collegit. Fasc. 1:no. 1-no. 1830. 100p. Available online: https://books.google.com.au/books?id=GTZinQEACAAJ (accessed on 14 March 2023).
- Saccardo, P.A. Sylloge Fungorum Omnium Hucusque Cognitorum; 3. Pavia; Sumptibus Auctoris: Patavii, Italy, 1884; 860p. [Google Scholar]
- Boerema, G.H.; de Gruyter, J.; Noordeloos, M.E. Phoma identification manual. In Differentiation of Specific and Infra-Specific Taxa in Culture; CABI Publishing: Wallingford, UK, 2004; 470p. [Google Scholar]
- Chen, Q.; Jiang, J.R.; Zhang, G.Z.; Cai, L.; Crous, P.W. Resolving the Phoma enigma. Stud. Mycol. 2015, 82, 137–217. [Google Scholar] [CrossRef] [PubMed]
- De Gruyter, J.; Aveskamp, M.M.; Woudenberg, J.H.; Verkley, G.J.; Groenewald, J.Z.; Crous, P.W. Molecular phylogeny of Phoma and allied anamorph genera: Towards a reclassification of the Phoma complex. Mycol. Res. 2009, 113, 508–519. [Google Scholar] [CrossRef] [PubMed]
- Chen, Q.; Hou, L.W.; Duan, W.J.; Crous, P.W.; Cai, L. Didymellaceae revisited. Stud. Mycol. 2017, 87, 105–159. [Google Scholar] [CrossRef]
- Hou, L.W.; Groenewald, J.Z.; Pfenning, L.H.; Yarden, O.; Crous, P.W.; Cai, L. The Phoma-like dilemma. Stud. Mycol. 2020, 96, 309–396. [Google Scholar] [CrossRef]
- Crous, P.W.; Hawksworth, D.L.; Wingfield, M.J. Identifying and naming plant-pathogenic fungi: Past, present, and future. Annu. Rev. Phytopathol. 2015, 53, 247–267. [Google Scholar] [CrossRef]
- Ahmadpour, S.A.; Mehrabi-Koushki, M.; Farokhinejad, R.; Asgari, B. New species of the family Didymellaceae in Iran. Mycol. Prog. 2022, 21, 28. [Google Scholar] [CrossRef]
- Chen, T.; Wang, S.; Jiang, X.; Huang, Y.; Mo, M.; Yu, Z. New species of Didymellaceae within aquatic plants from Southwestern China. J. Fungi. 2023, 9, 761. [Google Scholar] [CrossRef] [PubMed]
- Mel’nik, V.A. Opredelitel’ Gribov Roda Ascochyta Lib; Nauka: Leningrad, Russia, 1977; 246p. [Google Scholar]
- Boerema, G.H.; Bollen, G.J. Conidiogenesis and conidial septation as differentiating criteria between Phoma and Ascochyta. Persoonia 1975, 8, 111–444. [Google Scholar]
- Holm, L.G.; Plucknett, D.L.; Pancho, J.V.; Herberger, J.P. The World’s Worst Weeds: Distribution and Biology; HI University Press: Honolulu, HI, USA, 1977; 609p. [Google Scholar]
- Farr, D.F.; Rossman, A.Y. Fungal Databases, Systematic Mycology and Microbiology Laboratory. Agricultural Research Service United States Department of Agriculture. Available online: http://nt.ars-grin.gov/fungaldatabases/ (accessed on 14 March 2023).
- Wehmeyer, L.E. Some fungi imperfecti of the Punjab and Kashmir. Hycologia 1964, 56, 29–52. [Google Scholar] [CrossRef]
- Heiny, D.K. Phoma proboscis sp.nov. pathogenic on Convolvulus arvensis. Mycotaxon 1990, 36, 457–471. [Google Scholar]
- Gomzhina, M.M.; Gasich, E.L.; Khlopunova, L.B.; Gannibal, P.B. Paraphoma species associated with Convolvulaceae. Mycol. Prog. 2020, 19, 185–194. [Google Scholar] [CrossRef]
- Samson, R.A.; Hoekstra, E.S.; Frisvad, J.C.; Filtenborg, O. Introduction to Food- and Airborne Fungi, 6th ed.; Centraal Bureau Voor Schimmel Cultures: Utrecht, The Netherlands, 2002; 389p. [Google Scholar]
- Doyle, J.J.; Doyle, J.L. A rapid total DNA preparation procedure for fresh plant tissue. Focus 1990, 12, 13–15. [Google Scholar]
- Gardes, M.; Bruns, T.D. ITS primers with enhanced specificity for Basidiomycetes application to the identification of mycorrhizae and rusts. Mol. Ecol. 1993, 2, 113–118. [Google Scholar] [CrossRef] [PubMed]
- White, T.J.; Bruns, T.; Lee, S.; Taylor, J. Amplification and direct sequencing of fungal ribosomal RNA genes for phylogenetics. In PCR Protocols: A Guide to Methods and Applications; Innis, M.A., Gelfand, D.H., Sninsky, J.J., White, T.J., Eds.; Academic Press: San Diego, CA, USA, 1990; pp. 315–322. [Google Scholar]
- Rehner, S.A.; Samuels, G.J. Taxonomy and phylogeny of Gliocladium analysed from nuclear large subunit ribosomal DNA sequences. Mycol. Res. 1994, 98, 625–634. [Google Scholar] [CrossRef]
- Sung, G.H.; Sung, J.M.; Hywel-Jones, N.L.; Spatafora, J.W. A multi-gene phylogeny of Clavicipitaceae (Ascomycota, Fungi): Identification of localized incongruence using a combinational bootstrap approach. Mol. Phylogenet. Evol. 2007, 44, 1204–1223. [Google Scholar] [CrossRef] [PubMed]
- Liu, Y.J.; Whelen, S.; Hall, B.D. Phylogenetic relationships among ascomycetes: Evidence from an RNA polymerse II subunit. Mol. Biol. Evol. 1999, 16, 1799–1808. [Google Scholar] [CrossRef] [PubMed]
- Aveskamp, M.M.; Verkley, G.J.; de Gruyter, J.; Murace, M.A.; Perello, A.; Woudenberg, J.H.; Groenewald, J.Z.; Crous, P.W. DNA phylogeny reveals polyphyly of Phoma section Peyronellaea and multiple taxonomic novelties. Mycologia 2009, 101, 363–382. [Google Scholar] [CrossRef] [PubMed]
- Boyle, J.S.; Lew, A.M. An inexpensive alternative to glassmilk for DNA purification. Trends Genet. 1995, 11, 8. [Google Scholar] [CrossRef] [PubMed]
- Sanger, F.; Nicklen, S.; Coulson, A.R. DNA sequencing with chain-terminating inhibitors. Proc. Natl. Acad. Sci. USA 1977, 74, 5463–5467. [Google Scholar] [CrossRef]
- Thompson, J.D.; Gibson, T.J.; Plewniak, F.; Jeanmougin, F.; Higgins, D.G. The CLUSTAL_X windows interface: Flexible strategies for multiple sequence alignment aided by quality analysis tools. Nucleic Acids Res. 1997, 25, 4876–4882. [Google Scholar] [CrossRef]
- Kumar, S.; Stecher, G.; Li, M.; Knyaz, C.; Tamura, K. MEGA X: Molecular Evolutionary Genetics Analysis across computing platforms. Mol. Biol. Evol. 2018, 35, 1547–1549. [Google Scholar] [CrossRef] [PubMed]
- Vaidya, G.; Lohman, D.J.; Meier, R. SequenceMatrix: Concatenation software for the fast assembly of multi-gene datasets with character set and codon information. Cladistics 2011, 27, 171–180. [Google Scholar] [CrossRef] [PubMed]
- Minh, B.Q.; Schmidt, H.A.; Chernomor, O.; Schrempf, D.; Woodhams, M.D.; Von Haeseler, A.; Lanfear, R. IQ-TREE 2: New models and efficient methods for phylogenetic inference in the genomic era. Mol. Biol. Evol. 2020, 35, 1530–1534. [Google Scholar] [CrossRef] [PubMed]
- Lord, E.; Leclercq, M.; Boc, A.; Diallo, A.B.; Makarenkov, V. Armadillo 1.1: An original workflow platform for designing and conducting phylogenetic analysis and simulations. PLoS ONE. 2012, 7, e29903. [Google Scholar] [CrossRef]
- Heiny, D.K. Host-specificity of Phoma proboscis in the Convolvulaceae. Phytopathology 1992, 82, 498. [Google Scholar]
- Saccardo, P.A. Sylloge Fungorum Omnium Hucusque Cognitorum; 11(3); R. Friedländer & Sohn: Berlin, Germany, 1895; 753p. [Google Scholar]
- Morgan-Jones, C. Studies in the genus Phoma. XV. Concerning Phoma multirostrata, a leaf spot- inducing and soil-borne species in warm climates. Mycotaxon 1988, 33, 339–351. [Google Scholar]
- Larki, R.; Mehrabi-Koushki, M.; Farokhinejad, R. Ectophoma iranica sp. nov. and new hosts and recods of Allophoma spp. in Iran. J. Phytopathol. 2019, 167, 538–545. [Google Scholar] [CrossRef]
- Ormeno-Nuñez, J.; Reeleder, R.D.; Watson, A.K. A new species of Phomopsis recovered from field bindweed (Convolvulus arvensis). Can. J. Bot. 1988, 66, 2228–2233. [Google Scholar] [CrossRef]
- Ormeno-Nuñez, J.; Reeleder, R.D.; Watson, A.K. A foliar disease of field bindweed (Convolvulus arvensis) caused by Phomopsis convolvulus. Plant Dis. 1988, 72, 338–342. [Google Scholar] [CrossRef]
- Vogelsang, S.; Watson, A.K.; DiTommaso, A. Effect of moisture, inoculum production, and planting substrate on disease reaction of field bindweed (Convolvulus arvensis L.) to the fungal pathogen, Phomopsis convolvulus. Eur. J. Plant Pathol. 1998, 104, 253–262. [Google Scholar] [CrossRef]
- Watson, A.K.; Reeleder, R.D.; Ormeno-Nuñez, J. Fungal Herbicides. U.S. Patent 5212086, 18 May 1993. [Google Scholar]
- Heiny, D.K.; Templeton, G.E. Effects of spore concentration, temperature, and dew period on disease of field bindweed caused by Phoma proboscis. Phytopathol 1991, 81, 905–909. [Google Scholar] [CrossRef]
- Heiny, D.K.; Templeton, G.E. Method and compositions for the biological control of field bindweed. U.S. Patent 5391538, 21 February 1995. [Google Scholar]
- Défago, G.; Ammon, H.U.; Cagan, L.; Draeger, B.; Greaves, M.P.; Guntli, D.; Hoeke, D.; Klimes, L.; Lawrie, J.; Moënne-Loccoz, Y.; et al. Towards the biocontrol of bindweeds with a mycoherbicide. BioControl 2001, 46, 157–173. [Google Scholar] [CrossRef]
- Pfirter, H.A.; Defago, G. The potential of Stagonospora sp. as a mycoherbicide for field bindweed. Biocontrol. Sci. Tech. 1998, 8, 93–101. [Google Scholar] [CrossRef]
- Pfirter, H.A.; Guntli, D.; Ruess, M.; Defago, G. Preservation, mass production and storage of Stagonospora convolvuli, a bioherbicide candidate for field bindweed (Convolvulus arvensis). BioControl 1999, 44, 437–447. [Google Scholar] [CrossRef]

| Ascochyta Species | Strain ID | GenBank Accession Number | |||
|---|---|---|---|---|---|
| ITS | 28S | rpb2 | tub2 | ||
| A. amygdali | IRAN 2641C, T | OK257015 | OK257023 | - | OK247742 |
| A. astragalina | CBS 113797, T | KT389482 | KT389699 | MT018257 | KT389776 |
| A. benningiorum | CBS 144957, T | MN823581 | MN823432 | MN824606 | MN824755 |
| A. clinopodiicola | CBS 123524 | MN973587 | MN943793 | - | MT005693 |
| A. coronillae-emeri | MFLUCC 13-0820, T | MH069661 | MH069667 | MH069679 | MH069686 |
| A. erotica sp. nov. | MF-17.19, R | MH651544 | MH651585 | PP197204 | PP197203 |
| A. erotica sp. nov. | MF-17.20, T | MH651559 | MH651600 | PP197205 | MH725219 |
| A. erotica sp. nov. | MF-17.21, R | MH651545 | MH651586 | PP197206 | MH725220 |
| A. erotica sp. nov. | MF-17.23, R | MH651546 | MH651587 | PP197207 | MH725221 |
| A. erotica sp. nov. | MF-17.24, R | MH651547 | MH651588 | PP197208 | MH725222 |
| A. fabae | CBS 524.77 | GU237880 | GU237963 | MT018241 | GU237526 |
| A. flava | CGMCC 3.20067; LC 13574, T | MT229693 | MT229670 | MT239090 | MT249261 |
| A. herbicola | CBS 629.97, R | GU237898 | GU238083 | KP330421 | GU237614 |
| A. kamchatica | MF 010-031, T | MF065724 | MF065747 | MT293558 | MF065768 |
| A. koolunga | CBS 373.84 | KT389481 | KT389698 | KT389560 | KT389775 |
| A. lentis | CBS 370.84 | KT389474 | KT389691 | MT018246 | KT389768 |
| A. medicaginicola | CBS 112.53, T | GU237749 | GU238101 | MT018251 | GU237628 |
| A. neopisi | MFLU 16-0291, T | MT177918 | MT177945 | MT432201 | - |
| A. nigripycnidia | CBS 116.96, T | GU237756 | GU238118 | MT018253 | GU237637 |
| A. phacae | CBS 184.55, T | KT389475 | KT389692 | MT018255 | KT389769 |
| A. pilosella | CBS 583.97, T | MN973590 | MN943796 | MT018258 | MT005696 |
| A. pisi | CBS 122785, T | GU237763 | GU237969 | MT018244 | GU237532 |
| A. premilcurensis | MFLUCC 14-0518, T | KT326694 | KT326695 | - | - |
| A. rabiei | CBS 237.37, T | KT389479 | KT389696 | MT018256 | KT389773 |
| A. rosae | MFLUCC 15-0063, T | KY496751 | KY496731 | KY514409 | - |
| A. syringae | CBS 545.72 | KT389483 | KT389700 | MT018245 | KT389777 |
| A. viciae | CBS 451.68 | KT389484 | KT389701 | KT389562 | KT389778 |
| A. viciae-pannonicae | CBS 254.92 | KT389485 | KT389702 | MT018250 | KT389779 |
| A. viciae-villosae | CBS 255.92 | MN973584 | MN943790 | MT018249 | MT005690 |
| Phomatodes nebulosa | CBS 117.93 | GU237757 | GU238114 | KP330425 | GU237633 |
| Character Status Summary | ITS | 28S | rpb2 | tub2 | 4 Loci |
|---|---|---|---|---|---|
| Total characters | 447 | 828 | 596 | 295 | 2166 |
| Invariable characters | 402 | 817 | 437 | 226 | 1882 |
| Informative charactrers (%) | 18 | 2 | 98 | 46 | 164 |
| Uninformative characters | 27 | 9 | 61 | 23 | 120 |
| Nucleotide substitution models | K2 1 + G | K2 | K2 + G | K2 + G | TNe 2 + I + G4 |
| Tree length (TL) | 58 | 12 | 304 | 121 | 516 |
| Consistency index (CI) | 0.6563 | 0.6667 | 0.5272 | 0.5567 | 0.5166 |
| Homoplasy index (HI) | 0.3438 | 0.3333 | 0.4728 | 0.4433 | 0.4834 |
| Retention index (RI) | 0.8778 | 0.9286 | 0.7631 | 0.7923 | 0.7558 |
| Rescaled consistency index (RC) | 0.576 | 0.619 | 0.4023 | 0.4411 | 0.3905 |
| Isolate | Days of Growth | MEA | PDA | OA | ||||||
|---|---|---|---|---|---|---|---|---|---|---|
| 20 °C | 25 °C | 30 °C | 20 °C | 25 °C | 30 °C | 20 °C | 25 °C | 30 °C | ||
| P. proboscis ATCC 74032 1 | 4 | 11.5 | 7.5 | 5.0 | 15.0 | 7.0 | 5.0 | 15.0 | 12.0 | 5.0 |
| 7 | 24.0 | 7.5 | 5.0 | 29.0 | 7.0 | 5.0 | 34.0 | 12.5 | 5.0 | |
| 14 | 46.0 | 8.0 | 5.0 | 57.0 | 7.0 | 5.0 | 70.0 | 17.5 | 5.0 | |
| A. erotica MF-17.19 | 4 | 17.4 ± 0.4 | 19.5 ± 0.3 | 12.5 ± 0.5 | 22.4 ± 0.1 | 23.0 ± 0.4 | 17.5 ± 0.3 | 21.5 ± 0.5 | 19.8 ± 0.2 | 19.8 ± 0.5 |
| 7 | 28.0 ± 0.4 | 30.5 ± 0.9 | 17.4 ± 0.6 | 37.9 ± 0.3 | 39.0 ± 0.7 | 24.8 ± 0.2 | 34.8 ± 0.6 | 35.2 ± 0.2 | 27.0 ± 0.4 | |
| 14 | 57.5 ± 1.0 | 59.2 ± 0.6 | 30.0 ± 0.8 | 72.8 ± 0.8 | 77.8 + 0.6 | 40.8 ± 0.5 | 70.8 ± 0.8 | 75.0 ± 0.8 | 41.6 ± 0.6 | |
| A. erotica MF-17.20 | 4 | 18.1 ± 0.4 | 21.2 ± 0.2 | 14.0 ± 0.2 | 22.4 ± 0.2 | 26.0 ± 0.6 | 16.4 ± 0.1 | 23.0 ± 0.3 | 25.0 ± 0.5 | 15.5 ± 0.3 |
| 7 | 29.8 ± 0.1 | 32.8 ± 1.6 | 19.2 ± 0.5 | 39.0 ± 0.6 | 46.5 ± 0.6 | 22.4 ± 0.1 | 39.0 | 42.6 ± 0.9 | 23.1 ± 0.1 | |
| 14 | 60.5 ± 1.0 | 72.5 ± 0.9 | 30.4 ± 0.2 | 74.6 ± 1.2 | 80.0 | 36.9 ± 0.9 | 77.2 ± 1.9 | 80.0 | 39.8 ± 0.5 | |
| A. erotica MF-17.21 | 4 | 16.6 ± 1.3 | 19.2 ± 0.4 | 13.6 ± 0.2 | 21.9 ± 0.4 | 23.5 ± 0.3 | 16.1 ± 0.3 | 22.5 ± 0.4 | 19.8 ± 0.8 | 14.6 ± 0.6 |
| 7 | 30.4 ± 0.2 | 31.9 ± 0.4 | 19.2 ± 0.2 | 39.8 ± 0.8 | 42.5 ± 0.3 | 21.4 ± 0.4 | 38.5 ± 0.3 | 34.9 ± 1.0 | 19.6 ± 0.9 | |
| 14 | 63.1 ± 0.9 | 70.2 ± 1.6 | 33.2 ± 0.2 | 78.2 ± 0.8 | 77.5 ± 0.5 | 36.2 ± 0.2 | 75.8 ± 1.4 | 69.8 ± 0.6 | 39.4 ± 0.6 | |
| A. erotica MF-17.23 | 4 | 20.2 ± 0.8 | 22.6 ± 0.5 | 15.0 ± 0.4 | 24.8 ± 0.2 | 28.2 ± 0.2 | 20.1 ± 0.4 | 24.4 ± 0.5 | 25.1 ± 0.3 | 19.8 ± 0.2 |
| 7 | 36.1 ± 1.6 | 38.0 ± 0.8 | 20.5 ± 0.5 | 43.6 ± 0.4 | 48.0 ± 0.7 | 25.4 ± 0.6 | 43.4 ± 0.4 | 43.5 ± 0.3 | 28.8 ± 0.4 | |
| 14 | 71.5 ± 1.7 | 76.0 ± 1.5 | 33.0 ± 0.8 | 80.0 | 81.8 ± 0.2 | 45.0 ± 0.8 | 78.2 ± 1.2 | 79.5 ± 0.5 | 45.0 ± 0.6 | |
| A. erotica MF-17.24 | 4 | 21.3 ± 0.5 | 24.4 ± 0.4 | 14.5 ± 0.2 | 26.8 ± 0.2 | 30.8 ± 0.2 | 19.1 ± 0.1 | 22.8 ± 0.6 | 25.6 ± 0.7 | 17.8 ± 0.2 |
| 7 | 36.5 ± 0.3 | 40.0 ± 1.1 | 19.8 ± 0.2 | 46.2 ± 0.5 | 53.6 ± 0.2 | 26.8 ± 0.6 | 40.2 ± 0.2 | 45.0 ± 0.4 | 24.4 ± 0.8 | |
| 14 | 64.8 ± 3.4 | 69.0 ± 3.5 | 28.8 ± 0.5 | 79.4 ± 0.6 | 80.0 | 39.9 ± 0.6 | 77.5 ± 0.6 | 80.0 | 38.8 ± 0.5 | |
| Isolate | Diameter of Necrosis, mm (3, 4, and 7 dpt *) | |||
|---|---|---|---|---|
| Adaxial Side | Abaxial Side | |||
| Intact | Wounded | Intact | Wounded | |
| MF-17.19 | 0; 1.5 ± 0.9 **; 8.6 ± 2.5 | 4.0 ± 0.2; 6.5 ± 0.3; 13.0 ± 0.6 | 2.9 ± 0.5; 4.9 ± 0.4; 10.0 ± 0.4 | 4.2 ± 0.2; 6.2 ± 0.1; 10.0 ± 0.4 |
| MF-17.20 | 0; 0.8 ± 0.4; 6.6 ± 0.4 | 3.9 ± 0.3; 5.5 ± 0.2; 11.5 ± 0.3 | 4.1 ± 0.4; 5.6 ± 0.2; 9.8 ± 0.6 | 5.4 ± 0.2; 6.9 ± 0.2; 11.2 ± 0.5 |
| MF-17.21 | 0; 0; 1.6 ± 0.5 | 2.0; 4.0 ± 0.2; 9.4 ± 0.6 | 1.1 ± 0.7; 2.9 ± 0.9; 6.0 ± 0.6 | 3.8 ± 0.1; 4.4 ± 0.2; 8.8 ± 0.5 |
| MF-17.23 MF-17.24 | 0; 0; 5.4 ± 1.8 0; 0; 2.1 ± 1.2 | 3.5 ± 0.4; 4.9 ± 0.4; 10.0 ± 1.1 1.4 ± 0.1; 1.9 ± 0.1; 5.3 ± 0.3 | 4.8 ± 0.5; 6.1 ± 0.4; 9.6 ± 0.6 0; 0; 5.0 ± 0.9 | 5.1 ± 0.1; 6.0; 9.5 ± 0.3 2.2 ± 0.2; 2.9 ± 0.4; 4.8 ± 0.6 |
Disclaimer/Publisher’s Note: The statements, opinions and data contained in all publications are solely those of the individual author(s) and contributor(s) and not of MDPI and/or the editor(s). MDPI and/or the editor(s) disclaim responsibility for any injury to people or property resulting from any ideas, methods, instructions or products referred to in the content. |
© 2024 by the authors. Licensee MDPI, Basel, Switzerland. This article is an open access article distributed under the terms and conditions of the Creative Commons Attribution (CC BY) license (https://creativecommons.org/licenses/by/4.0/).
Share and Cite
Gomzhina, M.; Gasich, E. Ascochyta erotica sp. nov. Pathogenic on Convolvulus arvensis. Diversity 2024, 16, 246. https://doi.org/10.3390/d16040246
Gomzhina M, Gasich E. Ascochyta erotica sp. nov. Pathogenic on Convolvulus arvensis. Diversity. 2024; 16(4):246. https://doi.org/10.3390/d16040246
Chicago/Turabian StyleGomzhina, Maria, and Elena Gasich. 2024. "Ascochyta erotica sp. nov. Pathogenic on Convolvulus arvensis" Diversity 16, no. 4: 246. https://doi.org/10.3390/d16040246





